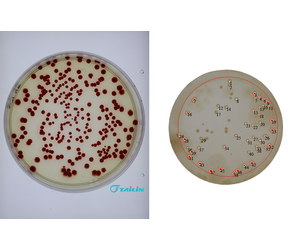

- Home
- Companies
- Zhejiang Tailin Bioengineering Co., ...
- Products
- Tailin - Model ASC-200 - Automatic ...

Tailin - Model ASC-200 -Automatic Colony Counter
Colony Counter for Microbial Test (automatic colony counter ASC-2000 ) consists of a colony counting machine, a high-performance all-in-one computer and a barcode scanner.
- "Zero-click" operation: automatically recognize the counting area, instant shooting
- Convenient operation: simple and clear system interface
- Lightning counting: 1000cfu per second
- Results high accuracy: internal and adherent areas of the culture dish are all counted;
- Use the Watershed algorithm to segment fusion colonies to ensure accurate results
- Flexible design: suitable for multi-size, different models of culture dishes
- Sterilization function: UV disinfection and sterilization to avoid cross-contamination
- Scan recording: supports QR code or barcode recording
- Ultra-high definition camera: 20 million pixels

-12 million pixel lens
-1.1" large target surface, wide field of view (150*150mm)
-Counting for Multi-size culture dishes
-SONY IMX183 series CMOS
-20 million pixel color high-definition camera
-1" photosensor, clearer shooting, and more abundant details

-English version, user-friendly software interface
-Two modes for selection: petri dish with membrane & normal petri dish
-Advanced image processing algorithm: better determining, segmenting and counting of the colony
-Can be connected with LIMIS system
-Conform to 21 CFR Part 11 requirements
-Result traceability: photo storage in the computer
-Result export: pdf, jpg, bmp, png, exce

The bottom backlight and the left and right side light sources are arranged with high-density LEDs, matched with a nano-level diffuse reflector, the light is soft,
and the colonies from the center to the edge can be uniformly illuminated to highlight the outline.

-Simple metal chassis
-Drop-down hovering board in the chamber to effectively block the interference of ambient light and ensure the imaging effect
-In-built 254nm UV lamp, can kill the internal contaminated colonies and meet the needs of ultraviolet mutagenesis of special bacteria
-Pulling down the hovering board can effectively block UV rays to ensure safe use
Tailin Colony Counter for Microbial Test (ASC-2000) can be widely used in biopharmaceuticals, medical and health care, inspection and quarantine, food safety, life sciences, air quality monitoring and water quality monitoring, etc.


